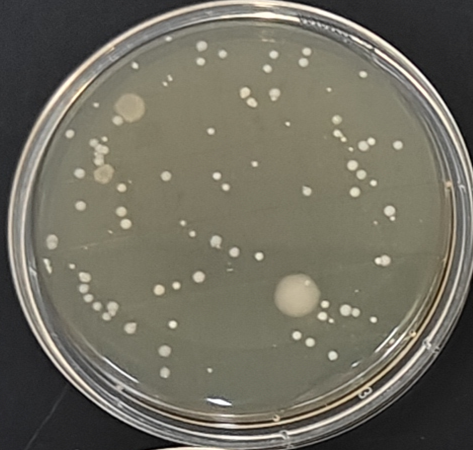
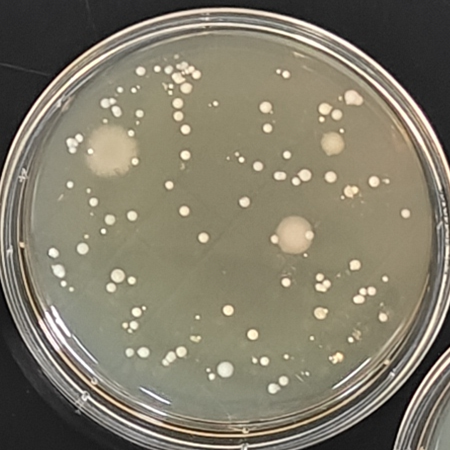
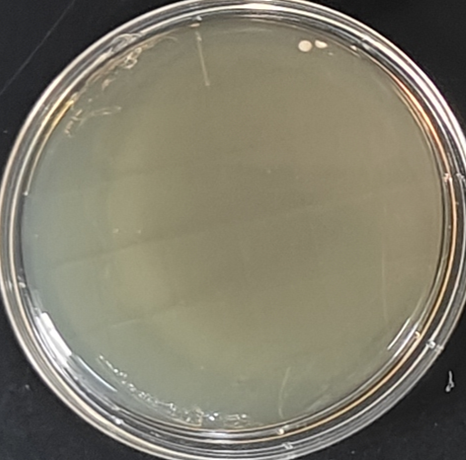

海博微信公众号
海博微信公众号
 海博天猫旗舰店
海博天猫旗舰店


 海博微信公众号
海博微信公众号
 海博天猫旗舰店
海博天猫旗舰店




一.我们日常接触的“脏”设备
在数字时代,智能手机和电脑键盘已成为我们日常生活中不可或缺的工具。从清晨的第一条消息查看,到深夜的最后一次社交媒体浏览,这些设备几乎与我们形影不离。然而,就在我们指尖频繁触碰的这些光滑表面上,一个看不见的微生物世界正在蓬勃发展。有一种说法,手机屏幕上的细菌数量可能比公共厕所座便器多出十倍以上,而电脑键盘则可能藏匿着从普通感冒病毒到金黄色葡萄球菌等各种微生物。
二.手机上复杂的微生物群落
智能手机已成为现代人最私密的物品之一,我们吃饭时用它看视频,上厕所时刷社交媒体,甚至生病时也离不开它。这种高频率、多场景的使用方式使手机成为了细菌传播的理想载体。手机上的细菌种类繁多,主要包括以下几种:首先是葡萄球菌属(Staphylococcus),尤其是金黄色葡萄球菌(S.aureus),这种细菌通常存在于皮肤和鼻腔中,可通过接触传播到手机表面。虽然大多数情况下无害,但某些菌株可能导致皮肤感染、食物中毒甚至更严重的疾病如肺炎。其次是大肠杆菌(E.coli),这种通常与粪便污染相关的细菌出现在手机上,主要是因为人们在如厕后未彻底洗手就使用手机。此外,还有链球菌(Streptococcus)、假单胞菌(Pseudomonas)和棒状杆菌(Corynebacterium)等常见于人体皮肤和环境的微生物。
手机细菌的数量和种类受多种因素影响。使用频率越高,细菌负荷通常越大;使用环境也很关键,医院、厨房和浴室等场所使用手机会显著增加细菌种类;个人卫生习惯则是决定性因素,洗手频率低的人其手机上的致病菌比例往往更高。值得注意的是,手机壳材质也影响细菌滋生,橡胶和塑料壳比金属或玻璃材质更容易积累微生物,因为多孔表面为细菌提供了更多藏身之处。
空说无凭,为验证以上说法,使用接触皿分别接触手机机身表面、手机壳,然后于36℃培养18 h-24 h,培养18 h的结果如图1所示。
|
 |
 |
|
手机机身 |
手机壳 |
空白(下文不再展示) |
图1 手机机身和手机壳上的细菌
由图1可知,手机机身和手机壳上均检验出多种菌落形态的菌株,这说明手机上细菌种类繁多的说法并不是危言耸听。
三.电脑键盘:办公室里的细菌“热点”
与手机相比,电脑键盘的细菌问题同样严重,但由于多人共用、清洁频率低等特点,其微生物群落可能更为复杂。键盘细菌的主要来源有几个方面,首先是使用者本身,我们手上的细菌、皮肤细胞和汗液在打字过程中不断沉积在键帽之间;其次是办公环境中的污染物,如灰尘、食物残渣和飞沫等;多人共用键盘时,微生物交叉污染的风险显著增加。更令人担忧的是,许多人在办公桌前用餐,掉落的食物碎屑为细菌繁殖提供了丰富营养,而键盘的缝隙和凹凸表面则创造了理想的微生物栖息地。
键盘上常见的细菌有金黄色葡萄球菌、链球菌、肠球菌(Enterococcus)等,链球菌可能引发咽喉炎;肠球菌则与尿路感染有关;此外还有芽孢杆菌(Bacillus)和微球菌(Micrococcus)等环境常见菌种。除了细菌,键盘还可能藏有病毒,如流感病毒和诺如病毒,这些病原体在某些表面可存活数小时至数天。
键盘设计本身加剧了细菌问题。键帽之间的缝隙难以彻底清洁,许多人在清洁时只是简单擦拭键帽表面,而忽视了键帽下方和键盘底座。此外,静电吸附作用使键盘更容易积累灰尘和微生物颗粒,而塑料材质则可能形成生物膜,保护细菌免受清洁剂杀灭。键盘上的细菌测试如图2所示。
图2 电脑键盘上的细菌
由图2可知,电脑键盘上的细菌量也比较复杂,对比图1还可知,其菌量比手机还多。
四.细菌传播的健康风险
手机和键盘上的细菌虽然多数无害,但某些病原微生物确实可能对我们的健康构成威胁。最常见的风险是皮肤感染,如痤疮、毛囊炎和脓疱疮等,特别是当皮肤有微小破损时,接触污染设备后感染风险增加。经常将手机贴在面部通话可能导致面部痤疮恶化,这种现象被称为“手机痤疮”。
更严重的是,通过手-设备-口/眼/鼻的传播途径,致病微生物可能引发系统性感染。例如,触摸污染键盘后揉眼睛可能引发结膜炎;不洗手就进食可能导致胃肠道感染;而免疫力低下人群接触某些病原体后甚至可能出现肺炎或败血症等严重并发症。在医院环境中,污染的电子设备已成为医疗相关感染的重要传播媒介之一。
特定人群面临的风险更高。医护人员、教师和客服人员等频繁使用共享设备的人接触病原体的机会更多;儿童、老人和慢性病患者等免疫力较弱的人群感染后果可能更严重;而有伤口或皮肤问题的人也更容易发生局部感染。值得注意的是,抗生素耐药菌株的出现使得这些看似普通的感染变得更加难以治疗,凸显了预防性清洁的重要性。
虽然健康风险确实存在,但也不必过度恐慌。人体免疫系统通常能够应对日常接触的多数微生物,且感染发生需要一定数量的病原体突破防御。关键在于保持良好的设备卫生习惯,特别是高危人群和有疫情发生时,以降低风险而非追求无菌环境为目标。
五.有效清洁与预防策略
面对手机和键盘上的细菌问题,采取适当而非过度的清洁措施至关重要。对于智能手机,可以每天清洁一次,在高风险环境(如医院)使用后应立即清洁。正确的清洁方法包括:先用超细纤维布轻轻擦拭去除表面灰尘;然后使用含70%异丙醇的消毒湿巾或少量肥皂水轻轻擦拭表面(避免过多液体渗入设备);最后用干布擦干。避免使用漂白剂、研磨剂或过氧化氢等强腐蚀性物质,这些可能损坏屏幕的疏油层。
键盘清洁需要更细致的方法。日常维护包括每周用压缩空气清理键帽间碎屑;每月用微湿的消毒布擦拭键帽表面;对于深度清洁,可以考虑每季度拆下键帽用温和清洁剂清洗。特殊情况下,如多人共用键盘或流感季节,应增加清洁频率。
除了定期清洁,预防细菌滋生的行为习惯同样重要。避免在如厕时使用手机,不在电脑前饮食,使用设备前后洗手,鼓励使用耳机或扬声器模式减少手机与面部的接触。
值得注意的是,不必因此变得焦虑,试验人员如果能做到试验结束后,及时清洁手机等,哪怕是简单几十秒的擦拭,也会有立竿见影的杀菌效果。为对比清洁前后效果,在图1、图2的基础上,使用含75%酒精的湿巾分别对手机机身、手机壳、电脑键盘进行清洁,然后再使用接触皿检验菌数,如图3所示。
|
 |
 |
|
手机机身 |
手机壳 |
电脑键盘 |
图3 清洁后的设备表面情况
由图3对比图1~图2可知,对手机机身、手机壳、电脑键盘清洁后,其表面的菌量大大下降,起到了有效的清洁作用。
注:本文属海博生物原创,未经允许不得转载。
上一篇:极端嗜盐菌知多少
下一篇:没有了!
| 相关文章: | |



